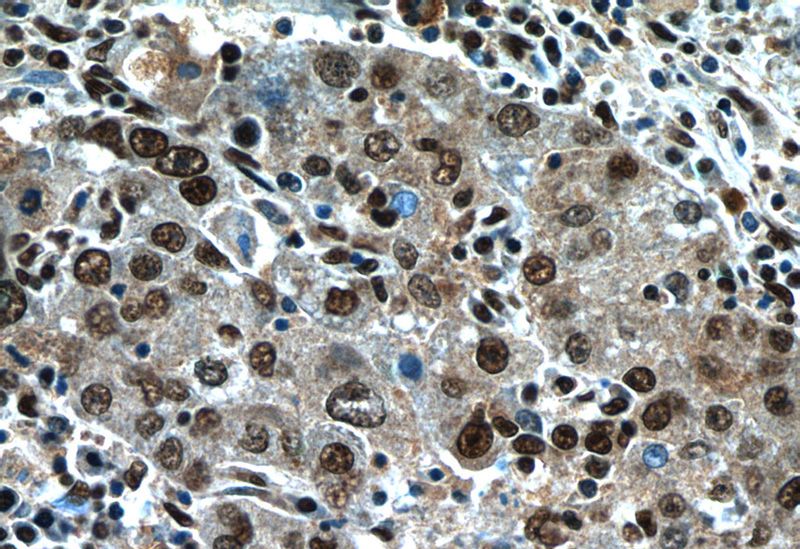
Immunohistochemistry of paraffin-embedded human liver cancer tissue slide using Catalog No:113157(NFKB2 Antibody) at dilution of 1:50 (under 40x lens)
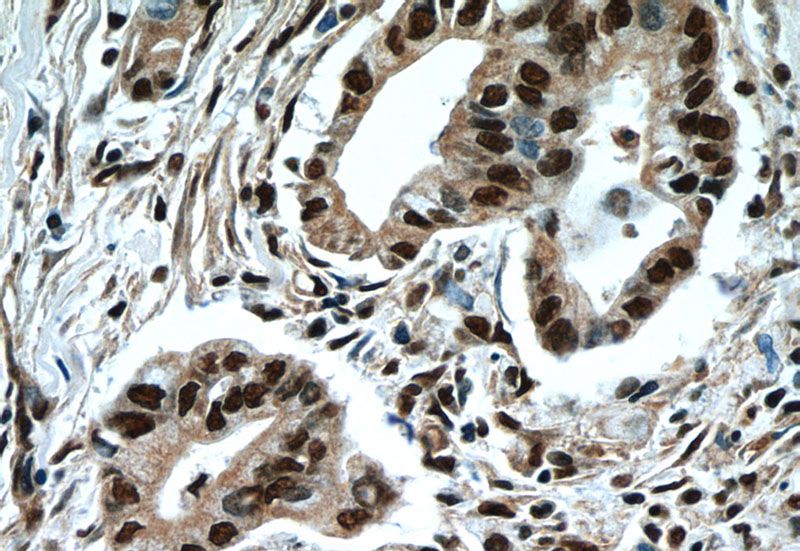
Immunohistochemistry of paraffin-embedded human pancreas cancer tissue slide using Catalog No:113157(NFKB2 Antibody) at dilution of 1:50 (under 40x lens)

-
Product Name
NFKB2 antibody
- Documents
-
Description
NFKB2 Rabbit Polyclonal antibody. Positive WB detected in multi-cells, HeLa cells. Positive IP detected in K-562 cells. Positive IHC detected in human pancreas cancer tissue, human liver cancer tissue. Positive IF detected in HeLa cells. Observed molecular weight by Western-blot: 105kd
-
Tested applications
ELISA, IHC, WB, IF, IP
-
Species reactivity
Human,Mouse,Rat; other species not tested.
-
Alternative names
DNA binding factor KBF2 antibody; H2TF1 antibody; LYT 10 antibody; LYT10 antibody; NFKB2 antibody; NFKB2 antibody; p100 antibody; NFKB2 antibody; p52 antibody; p100 antibody; Oncogene Lyt 10 antibody; p100 antibody; p52 antibody
-
Isotype
Rabbit IgG
-
Preparation
This antibody was obtained by immunization of NFKB2 recombinant protein (Accession Number: NM_001261403). Purification method: Antigen affinity purified.
-
Clonality
Polyclonal
-
Formulation
PBS with 0.1% sodium azide and 50% glycerol pH 7.3.
-
Storage instructions
Store at -20℃. DO NOT ALIQUOT
-
Applications
Recommended Dilution:
WB: N/AIP: 1:200-1:2000
IHC: 1:20-1:200
IF: 1:10-1:100
-
Validations

WB result of Catalog No:113157(NFKB2 antibody).

IP Result of anti-NFKB2 (IP:Catalog No:113157, 4ug; Detection:Catalog No:113157 1:600) with K-562 cells lysate 1200ug.
Immunohistochemistry of paraffin-embedded human liver cancer tissue slide using Catalog No:113157(NFKB2 Antibody) at dilution of 1:50 (under 40x lens)
Immunohistochemistry of paraffin-embedded human pancreas cancer tissue slide using Catalog No:113157(NFKB2 Antibody) at dilution of 1:50 (under 40x lens)

Immunofluorescent analysis of HeLa cells using Catalog No:113157(NFKB2 Antibody) at dilution of 1:25 and Alexa Fluor 488-congugated AffiniPure Goat Anti-Rabbit IgG(H+L)
-
Background
NF-kappa-B is a pleiotropic transcription factor which is present in almost all cell types and is involved in many biological processed such as inflammation, immunity, differentiation, cell growth, tumorigenesis and apoptosis. NF-kappa-B is a homo- or heterodimeric complex formed by the Rel-like domain-containing proteins RELA/p65, RELB, NFKB1/p105, NFKB1/p50, REL and NFKB2/p52. NFKB2 appears to have dual functions such as cytoplasmic retention of attached NF-kappa-B proteins by p100 and generation of p52 by a cotranslational processing. The proteasome-mediated process ensures the production of both p52 and p100 and preserves their independent function. P52 binds to the kappa-B consensus sequence 5'-GGRNNYYCC-3', located in the enhancer region of genes involved in immune response and acute phase reactions. P52 and p100 are respectively the minor and major form; the processing of p100 being relatively poor. Isoform p49 is a subunit of the NF-kappa-B protein complex, which stimulates the HIV enhancer in synergy with p65. This antibody is a rabbit polyclonal antibody raised against residues near the C terminus of human NFKB2.
-
References
- Huang H, Zhong R, Xia Z, Song J, Feng L. Neuroprotective effects of rhynchophylline against ischemic brain injury via regulation of the Akt/mTOR and TLRs signaling pathways. Molecules (Basel, Switzerland). 19(8):11196-210. 2014.
- Tao X, Wan X, Xu Y. Dioscin attenuates hepatic ischemia-reperfusion injury in rats through inhibition of oxidative-nitrative stress, inflammation and apoptosis. Transplantation. 98(6):604-11. 2014.
Related Products / Services
Please note: All products are "FOR RESEARCH USE ONLY AND ARE NOT INTENDED FOR DIAGNOSTIC OR THERAPEUTIC USE"
